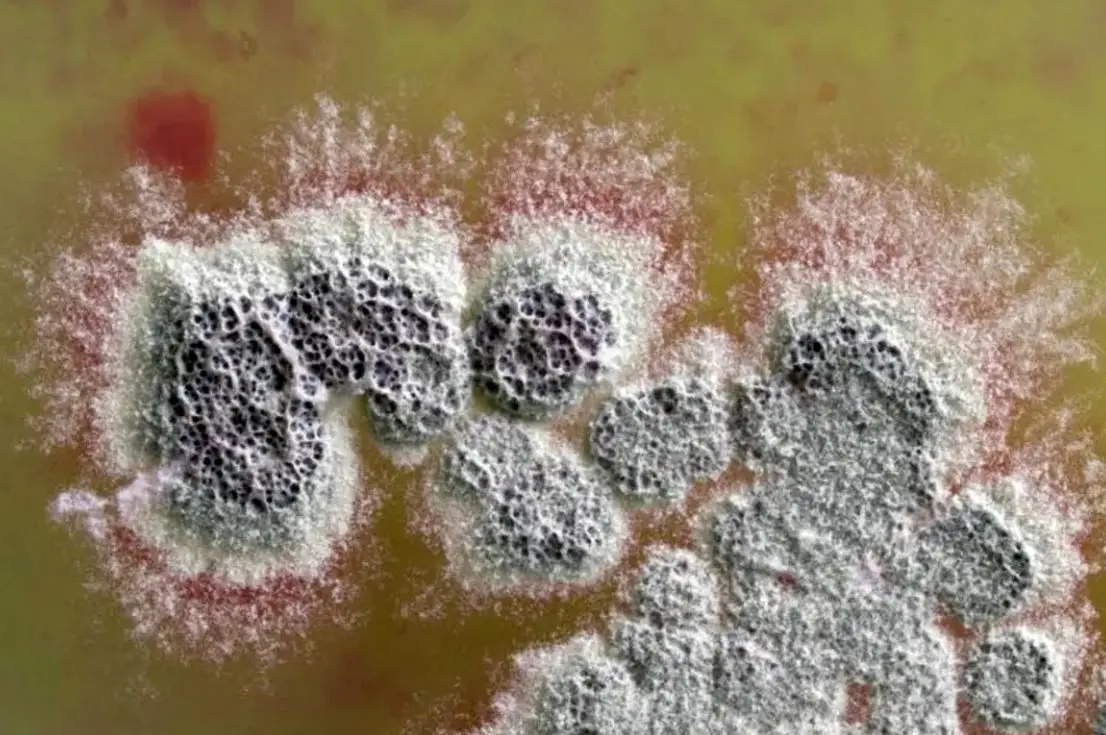
آنتی‌بیوتیک قدرتمندی که مقاوم‌ترین باکتری‌ها را نابود می‌کند

عضو هیئت علمی دانشگاه علوم پزشکی شیراز خطر تداخل دارویی وارفارین با آنتی بیوتیکها را در سالمندان حائز اهمیت دانست و گفت: این موضوع در سالمندان اهمیت بیشتری دارد، چراکه عملکرد دو ارگان دخیل در دفع دارو، شامل کبد و کلیه، در این سنین کاهش یافته و همزمانی مصرف چند دارو، احتمال بروز تداخلات را افزایش میدهد.